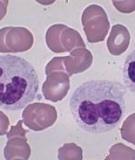

Tài liệu ôn tập Luật hình sự 2
-
Tài liệu "Đề thi học kì 2 môn Lịch sử nhà nước và pháp luật Việt Nam năm 2020-2021 - Trường ĐH Kinh tế-Luật" được tổng hợp nhằm hỗ trợ các bạn sinh viên trong quá trình ôn tập, giúp hệ thống lại kiến thức và rèn luyện kỹ năng giải bài tập một cách hiệu quả.
 1p
1p  laphongdo0906
laphongdo0906
 21-04-2025
21-04-2025
 1
1
 1
1
 Download
Download
-
Nhằm giúp các bạn có thêm tài liệu ôn tập, củng cố lại kiến thức đã học và rèn luyện kỹ năng làm bài tập, mời các bạn cùng tham khảo Đề thi kết thúc học phần học kì 2 môn Luật hình sự (phần các tội phạm) năm 2023-2024 có đáp án - Trường ĐH Văn Lang dưới đây. Hy vọng sẽ giúp các bạn tự tin hơn trong kỳ thi sắp tới.
 4p
4p  gaupanda072
gaupanda072
 06-02-2025
06-02-2025
 5
5
 2
2
 Download
Download
-
Đề thi kết thúc học phần học kì 2 môn Kỹ năng tranh tụng trong vụ án hình sự năm 2023-2024 có đáp án
Nhằm giúp các bạn có thêm tài liệu ôn tập, củng cố lại kiến thức đã học và rèn luyện kỹ năng làm bài tập, mời các bạn cùng tham khảo "Đề thi kết thúc học phần học kì 2 môn Kỹ năng tranh tụng trong vụ án hình sự năm 2023-2024 có đáp án - Trường ĐH Văn Lang" dưới đây. Hy vọng sẽ giúp các bạn tự tin hơn trong kỳ thi sắp tới.
 5p
5p  gaupanda072
gaupanda072
 06-02-2025
06-02-2025
 7
7
 1
1
 Download
Download
-
điều kiện ra đời và đặc trưng của sản suất hàng hóa? Hàng hóa và 2 thuộc tính của hàng hóa và mối quan hệ giữa chún lượng giá trị hàng hóa và các nhân tố ảnh hưởng? Các nội dung cơ bản của quy luật giá trị và tác động của nó? Phân tích sự chuyển hóa tiền thành TB?( Câu 9: Hàng hóa sức lao động, sức lđ, điều kiện để slđ trở thành hh, 2 thuộc tính của hàng hóa slđ? Câu 10: Sự thống nhất giữa qt sx ra gtrị sử dụng và qt sản xuất ra gtrị thăng...
 22p
22p  123thedu
123thedu
 04-08-2012
04-08-2012
 603
603
 129
129
 Download
Download
-
Đề cương ôn thi môn Luật hình sự 1 có đáp án tham khảo để các bạn sinh viên nghiên cứu, tham khảo cho kỳ thi của mình. Đề cương bao gồm bộ hơn 70 câu hỏi và đáp án. Mời các bạn cùng tham khảo để biết thêm nội dung chi tiết.
 44p
44p  cucngoainhan7
cucngoainhan7
 08-02-2022
08-02-2022
 115
115
 14
14
 Download
Download
-
Nhằm giúp các bạn học sinh có tài liệu ôn tập những kiến thức cơ bản, kỹ năng giải các bài tập nhanh nhất và chuẩn bị cho kì thi sắp tới được tốt hơn. Hãy tham khảo "Đề thi học kì 2 môn GDCD lớp 9 năm 2023-2024 có đáp án - Trường THCS Phù Đổng, Duy Xuyên" để có thêm tài liệu ôn tập. Chúc các em đạt kết quả cao trong học tập nhé!
 4p
4p  khanhchi2570
khanhchi2570
 29-05-2024
29-05-2024
 13
13
 2
2
 Download
Download
-
Đề thi học kì 1 môn Vật lí 2 năm 2016-2017 có đáp án - Trường Đại học sư phạm Kỹ thuật, TP HCM (CLC)
“Đề thi học kì 1 môn Vật lí 2 năm 2016-2017 có đáp án - Trường Đại học sư phạm Kỹ thuật, TP HCM (CLC)” giúp các bạn sinh viên có thêm tài liệu ôn tập, luyện tập giải đề nhằm nắm vững được những kiến thức, kĩ năng cơ bản, đồng thời vận dụng kiến thức để giải các bài tập một cách thuận lợi. Chúc các bạn thi tốt!
 5p
5p  viambani
viambani
 22-05-2024
22-05-2024
 10
10
 4
4
 Download
Download
-
Đề thi học kì 2 môn Vật lí 2 năm 2022-2023 có đáp án - Trường Đại học sư phạm Kỹ thuật, TP HCM (CLC)
Để đạt kết quả cao trong kì thi sắp tới, các em có thể tham khảo và tải về "Đề thi học kì 2 môn Vật lí 2 năm 2022-2023 có đáp án - Trường Đại học sư phạm Kỹ thuật, TP HCM " được TaiLieu.VN chia sẻ dưới đây để có thêm tư liệu ôn tập, luyện tập giải đề thi nhanh và chính xác giúp các em tự tin đạt điểm cao trong kì thi này. Chúc các em thi tốt!
 5p
5p  viambani
viambani
 22-05-2024
22-05-2024
 29
29
 3
3
 Download
Download
-
“Đề thi học kì 2 môn GDCD lớp 9 năm 2022-2023 - Trường THCS Đức Giang” giúp các bạn học sinh có thêm tài liệu ôn tập, luyện tập giải đề nhằm nắm vững được những kiến thức, kĩ năng cơ bản, đồng thời vận dụng kiến thức để giải các bài tập một cách thuận lợi. Chúc các bạn thi tốt!
 6p
6p  chankora09
chankora09
 28-06-2023
28-06-2023
 17
17
 3
3
 Download
Download
-
Nhằm giúp các bạn học sinh đang chuẩn bị cho kì thi giữa học kì 2 sắp diễn ra cũng như giúp các em củng cố và ôn luyện kiến thức, rèn kỹ năng làm bài thông qua việc giải “Đề thi giữa học kì 2 môn GDCD lớp 9 năm 2020-2021 có đáp án - Trường THCS Huỳnh Thị Lựu” dưới đây. Hi vọng đây là tài liệu hữu ích cho các bạn trong việc ôn tập. Chúc các bạn thi tốt!
 8p
8p  zhuzhengting_1803
zhuzhengting_1803
 19-03-2022
19-03-2022
 33
33
 1
1
 Download
Download
-
Tài liệu Hóa học lớp 10 - Chương 2: Bảng tuần hoàn các nguyên tố hóa học gồm có lý thuyết và bài tập vận dụng với hình thức trắc nghiệm. Mời các bạn cùng tham khảo để ôn tập và bổ sung kiến thức đạt hiệu quả cao.
 12p
12p  nhoctai59
nhoctai59
 26-09-2021
26-09-2021
 104
104
 7
7
 Download
Download
-
Đề cương ôn tập học kì 2 môn GDCD lớp 9 năm 2020-2021 - Trường THCS Gia Thụy giúp các em kiểm tra, đánh giá kiến thức của mình và có thêm thời gian chuẩn bị ôn tập cho kì thi sắp tới được tốt hơn. Và đây cũng là tài liệu phục vụ cho công tác giảng dạy, biên soạn đề thi của thầy cô. Mời quý thầy cô và các bạn cùng tham khảo đề cương.
 4p
4p  jingbairan
jingbairan
 29-04-2021
29-04-2021
 47
47
 2
2
 Download
Download
-
Đề cương ôn tập HK 2 môn Lịch sử 7 cung cấp cho các bạn những kiến thức tóm tắt và những câu hỏi bài tập giúp các bạn củng cố lại kiến thức và có thêm tài liệu học tập và ôn thi. Mời các bạn cùng tham khảo.
 3p
3p  huynhcao92
huynhcao92
 18-07-2018
18-07-2018
 69
69
 3
3
 Download
Download
-
Tài liệu sẽ giúp các em học sinh định hướng và gợi ý cách giải các bài tập 1,2,3 trang 38 nhằm giúp các em ôn tập và nắm vững hơn nội dung chính của bài học. Mời các em cùng tham khảo!
 2p
2p  tuyensinhhoc247_lop10
tuyensinhhoc247_lop10
 10-07-2017
10-07-2017
 98
98
 2
2
 Download
Download
-
Tài liệu Bộ đề thi môn: Luật hình sự (Học phần 1 + 2) giới thiệu đến các bạn 30 đề thi học phần môn Luật hình sự. Hi vọng tài liệu sẽ giúp ích cho các bạn trong quá trình học tập ôn thi học phần này. Để hiểu nắm vững cấu trúc cũng như nội dung đề thi mời các bạn cùng tham khảo tài liệu.
 10p
10p  phamthithuhuyen9b
phamthithuhuyen9b
 05-09-2016
05-09-2016
 291
291
 35
35
 Download
Download
-
Luật chứng khoán với việc mở rộng cơ hội đầu tư và khuyến khích đầu tư Quan niệm nguồn của pháp luật hình sự (theo nghĩa hẹp) chỉ là BLHS là quan niệm không còn phù hợp với xu thế và điều kiện hiện nay.
 4p
4p  tramoi_1
tramoi_1
 29-05-2013
29-05-2013
 241
241
 28
28
 Download
Download
-
1. Vi sinh học (microbiology) Là khoa học nghiên cứu các cơ thể sống hiển vi và siêu hiển vi, cấu tạo tế bào và quy luật hoạt động của chúng, sử dụng các vi sinh vật nhằm phục vụ lợi ích của con người và giữ vững hệ sinh thái trên trái đất. 2. Vi sinh vật (microorganisms) . Vi sinh vật là tên gọi chung để chỉ tất cả các sinh vật có hình thể bé nhỏ,...
 8p
8p  tieungot
tieungot
 23-01-2013
23-01-2013
 300
300
 70
70
 Download
Download
-
Liên Xô và sự sụp đổ của hệ thống xã hội chủ nghĩa thế giới , đã làm lộ rõ những khuyết tật của mô hình kinh tế cứng nhắc , phi thị trường , mặc dù những khuyết tật đó không phải là nguyên nhân tất yếu dẫn tới sự sụp đổ . Việt nam là một nước nghèo , kinh tế kỹ thuật lạc hâu , trình độ xã hội còn thấp , bị chiến tranh tàn phá nặng nề , di lên chủ nghĩa xã hội là mục tiêu lý tưởng của những người cộng sản và...
 9p
9p  caott9
caott9
 20-07-2011
20-07-2011
 129
129
 19
19
 Download
Download
-
Câu 1: 1. Hộ kinh doanh cá thể: Là loại hình doanh nghiệp có các đặc điểm sau: - Do một cá nhân, một nhóm người hoặc một hộ gia đình làm chủ sở hữu - Chủ sở hữu chịu trách nhiệm vô hạn bằng toàn bộ tài sản của mình đối với khoản nợ và nghĩa vị tài sản khác của hộ kinh doanh cá thể - Hộ kinh doanh không có tư cách pháp nhân và con dấu - Hộ kinh doanh không được sử dụng thường xuyên quá 10 lao động 2. Doanh nghiệp tư nhân: Là một loại hình doanh nghiệp được điều chỉnh bởi luật...
 18p
18p  nongdanpro
nongdanpro
 01-03-2011
01-03-2011
 2402
2402
 889
889
 Download
Download
-
1. Trường hợp nào sau đây được ghi vào sổ kế toán: a. ký hđ thuê nhà xưởng để sx. gtrị hđ 20tr/năm b. mua tscđ 50tr, chưa thanh toán c. nhận đc lệnh chi tiền phục vụ tiếp khách của dn 5tr (tiền chưa chi) d. tất cả trg hợp trên ĐÁP ÁN B 2. Đối tượng của kế toán là: a. tình hình thị trường, tình hình cạnh tranh S b. tài sản, nguồn vốn hình thành ts dn và sự vận động của chúng Đ c. tình hình thực hiện kỷ luật lđộng S d. tình hình thu chi tiền mặt (Đ mà chưa đủ, đtg kế...
 14p
14p  cindy1990
cindy1990
 03-09-2010
03-09-2010
 4297
4297
 2139
2139
 Download
Download
CHỦ ĐỀ BẠN MUỐN TÌM